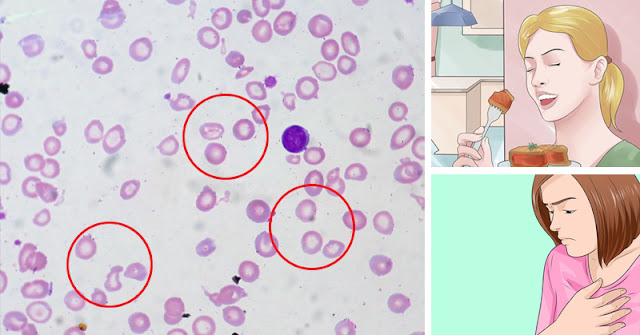

Publicitate
Data fiind necesitatea continua de vitamine, minerale si nutrienti pentru buna functionare a organismului, este chiar o minune cum uneori poate functiona la standardele bune.
Sa luam drept exemplu fierul, un mineral esential care echilibreaza oxigenarea sangelui. Deficitul de fier este foarte comun, insa daca nu suntem atenti la semne nu vom sti ca este cauza oboselii si energiei scazute.
Iata ce se petrece in organismul dumneavoastra atunci cand nu aveti un nivel suficient de fier si cum puteti remedia problema.
Exista mai multi factori care conduc la scaderea nivelului de fier: lipsa fierului din alimentatie, fara un consum crescut de legume si fructe organismul dumneavoastra nu poate functiona corect.
In plus, in perioada menstruatiei, femeile pot avea un nivel scazut de fier daca dureaza o perioada mai lunga de timp.
Deficitul de fier este des intalnit si in perioada sarcinii deoarece fatul absoarbe o cantitate destul de mare.
Ce se intampla cu organismul dumneavoastra atunci cand aveti lipsa de fier
Pur si simplu fierul este cel mai important nutrient din organism. Oxigenul pe care il respiram se uneste cu hemoglobina din sange. De aici hemoglobina duce oxigenul la toate organele din organism.
Daca aveti un deficit de fier, nu exista nici suficienta hemoglobina pentru a transporta oxigenul ducand astfel la un nivel scazut de oxigen in sange si in organe.
Odata cu trecerea timpului, se poate ajunge la simptome si efecte adverse. Un nivel scazut de oxigen poate inhiba energia determinand aparitia oboselii. In plus, un nivel scazut de fier va poate face nervos si morocanos. Anemia este adesea legata de un nivel scazut de fier.
Cum imbunatatim nivelul de fier
Daca suferiti de anemie, este important sa cresteti nivelul de fier si de oxigen. Exista mai multe metode prin care puteti face acest lucru. Uneori medicii prescriu suplimente pe baza de fier, insa acesta poate fi mai usor asimilat printr-o dieta sanatoasa.
Un numar foarte mare de alimente contin fier. Carnea rosie este o sursa nutritiva excelenta asa ca, bucurati-va din cand in cand de o friptura. Legumele cu frunze cum ar fi spanacul sau salata verde reprezinta o sursa bogata in fier. Poate sunteti surprinsi sa aflati ca se gaseste fier chiar si in ciocolata neagra.
Pentru barbati se recomanda un consum de 8.7 miligrame de fier pe zi iar pentru femei 14.8 miligrame pe zi.
Daca va veti imbunatatii dieta, veti observa si o crestere a energiei si o imbunatatire a sanatatii generale.
Cu drag,
Despre Autor:
Maria este autor pentrusuflet.com - "Doresc din inima ca articolele mele sa va atinga si sa va vindece sufletul si corpul, astfel incat impreuna, sa lasam un loc mai bun generatiilor viitoare". Pe Maria o puteti gasi si pe Facebook.
Publicitate
loading...
No comments:
Post a Comment